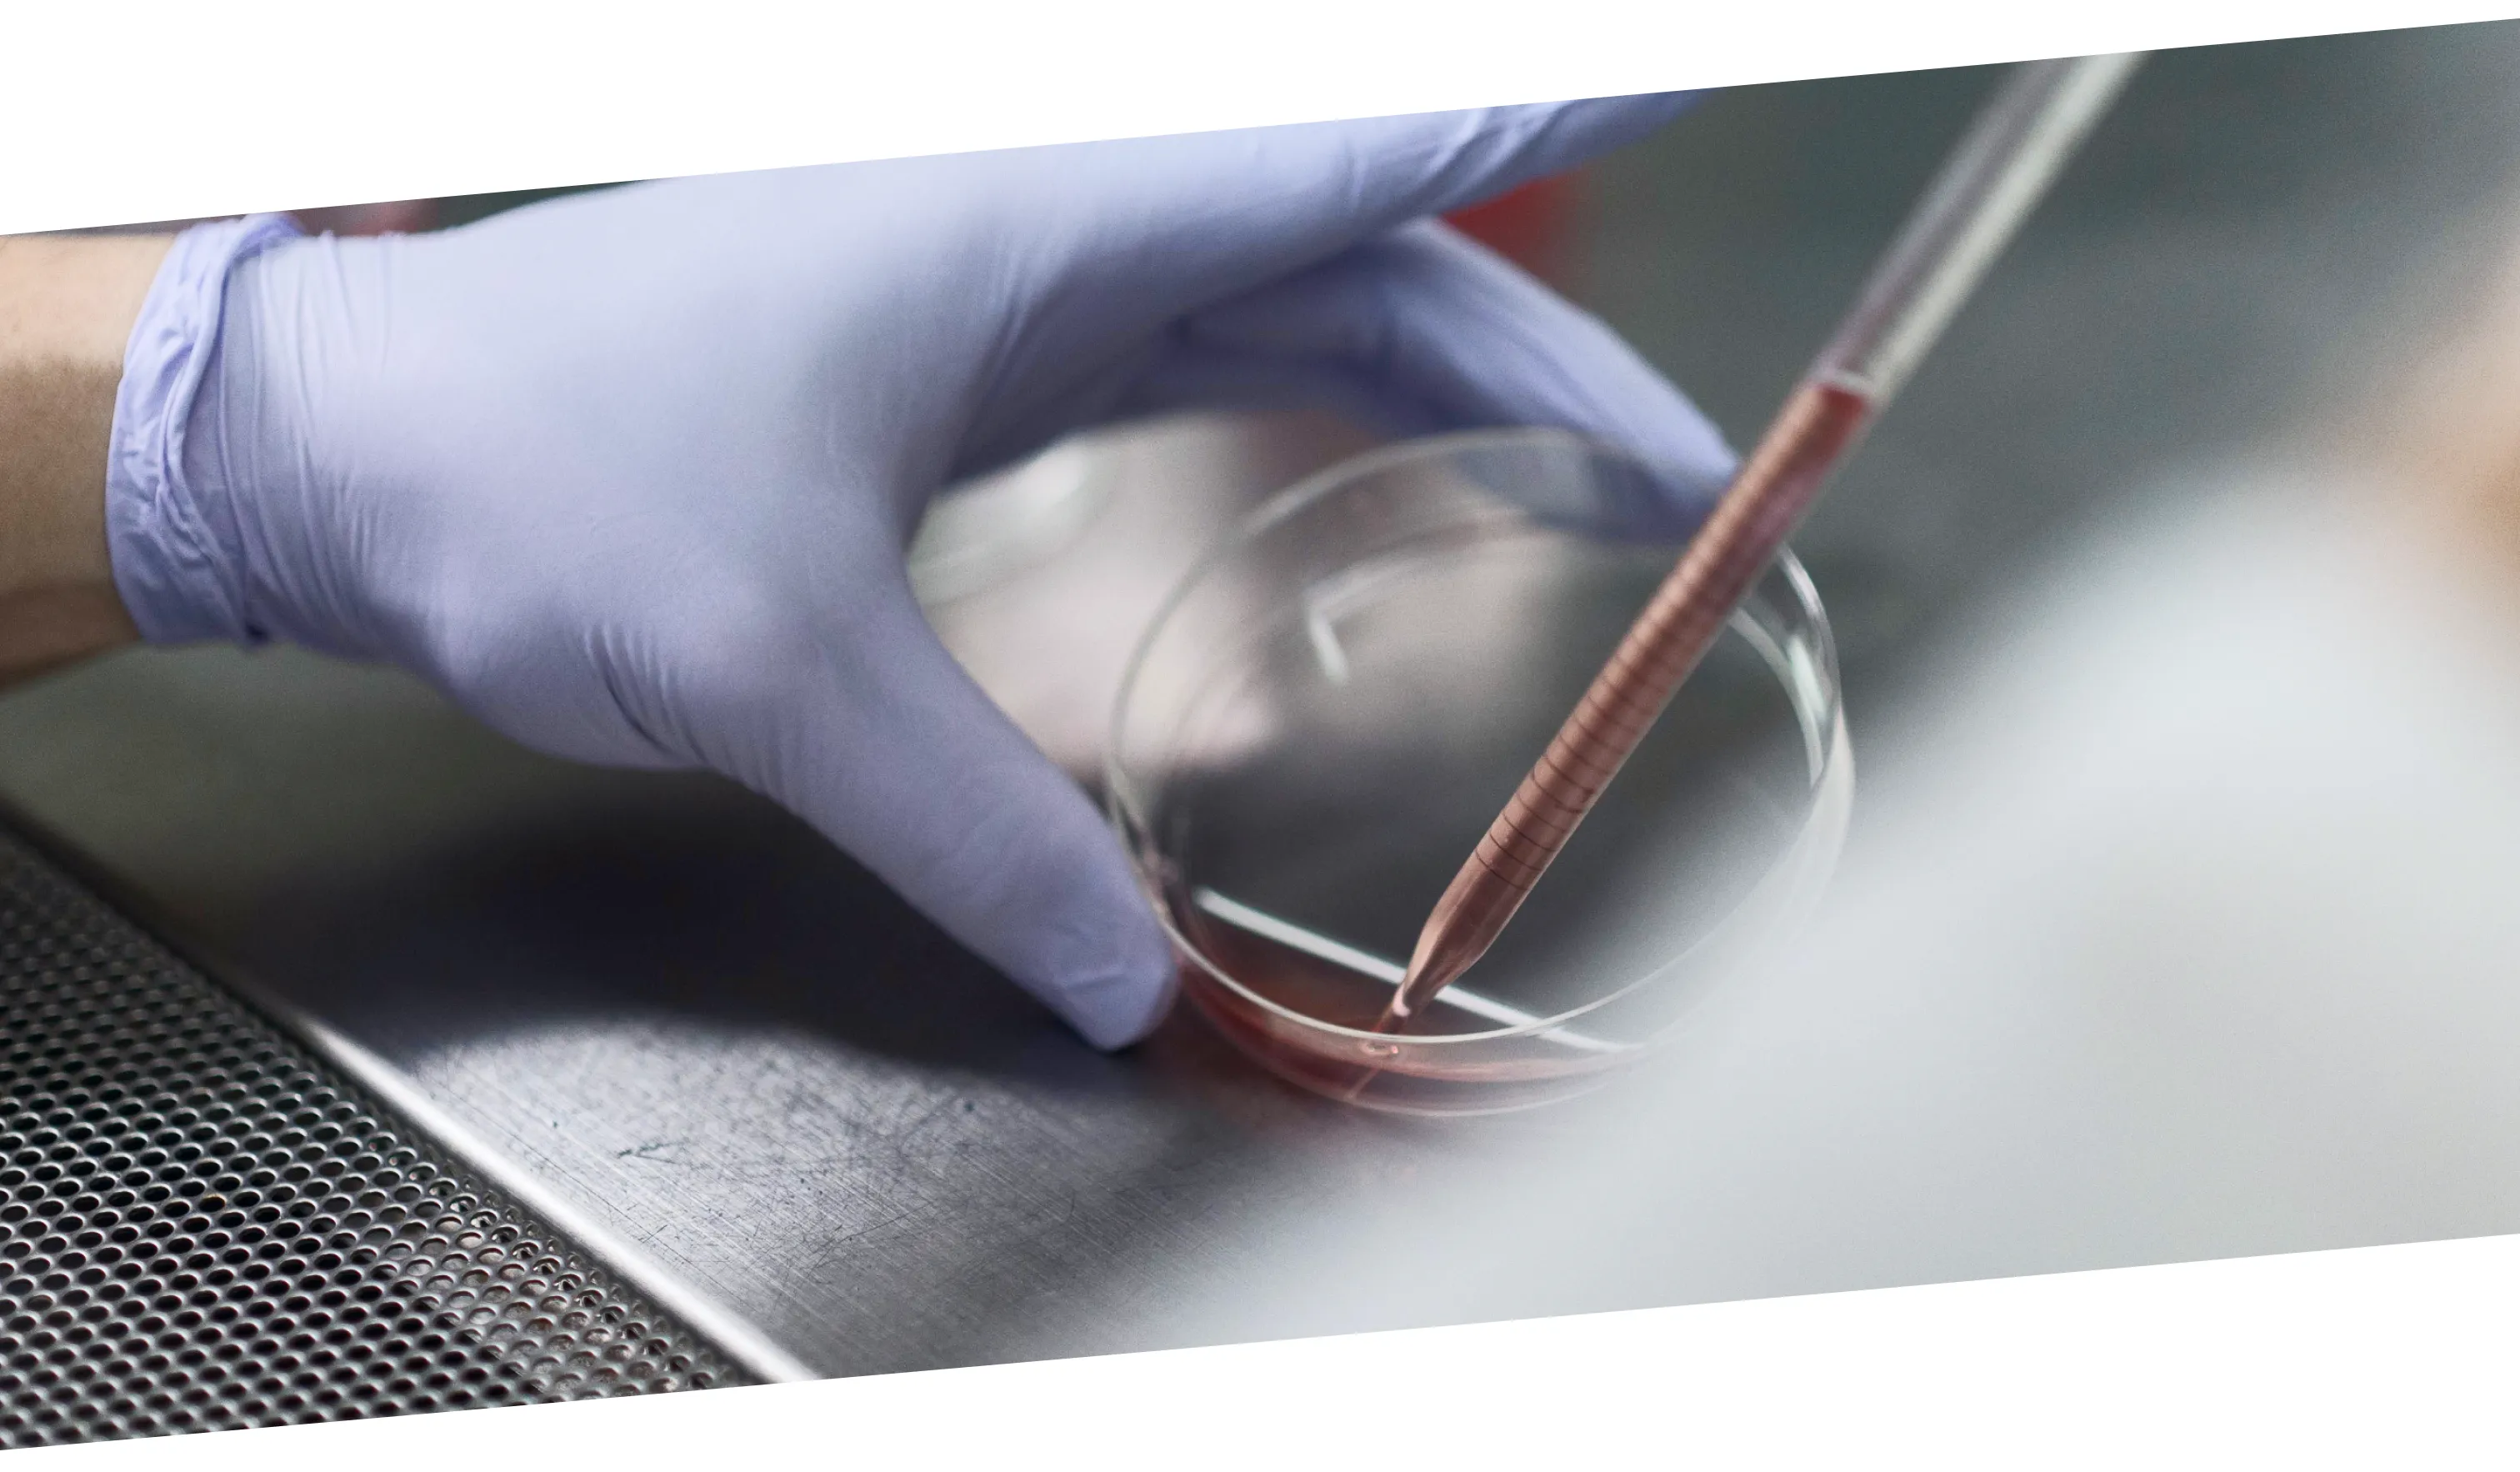

最先端の研究にふれ、最前線の現場に立つ。
そのすぐそばには、
迷ったときに声をかけてくれる先輩がいて、
つまづいた場面も、
一緒に振り返って前に進める仲間がいる。
できることを少しずつ増やしながら、
あなた自身の言葉で患者さまに向き合い、
あなた自身のやり方で、未来のキャリアを描いていく。
ここは、そんな日々があたりまえに続いていく場所です。
派手じゃないけれど、確かな「あなたの医師人生」が、
ここから動き出します。
あなたの今を支え、 これからを
一緒に考える医局
内視鏡や肝疾患、胆膵といった専門領域で、国内外から注目される研究実績があります。
でも、最初は「ちょっと興味がある」からで大丈夫。
一歩ずつ、着実に“できるようになる”経験が、ここにはあります。
-
成長実感
先端の診療・研究環境で“成長実感”を得られる
-
挑戦歓迎
若手の挑戦を歓迎する温かく手厚い指導文化
-
多様な働き方
キャリアやライフスタイルに合わせた多様な働き方
「学ぶ」が「積み重なる」場所を選ぼう

実臨床 × 手技 × 研究の三本柱
消化管・肝臓・膵胆道領域まで、多彩な症例に出会いながら、EGD・大腸内視鏡・ERCP・EUS・ESDなどの手技を段階的に身につけていきます。
若手でも研究や学会発表に取り組める環境があり、臨床と学術の両輪で成長できます。

前向きな「トライ」を、みんなで支える文化
「やってみたい」と手を挙げた人に、チャンスが回ってくる。その背景には、経験豊富な指導医のサポートと、互いに声を掛け合うチームの文化があります。
ひとりで悩む必要はありません。どんなことでも、誰かが一緒に考えてくれる場所です。



あなたの第一歩が、
ここに。
「まずは、内視鏡を触ってみたい」「将来、専門医として活躍したい」
そんな「最初のきっかけ」を、しっかり支える環境があります。
大分大学医学部消化器内科学講座では、初期研修・専門医研修の両段階で、豊富な症例・手技・指導体制を完備。
ここから、あなたのキャリアが動き出します。

専攻医研修の紹介
そして研究する知へ。
大学病院と関連病院のローテーションを通じて、臨床力と専門性を磨く3年間。
消化器病専門医・内視鏡専門医への道が、ここから本格的に開かれます。

女性医師の方へ
その両方に向き合う選択を。
結婚、出産、育児、介護——
人生の節目が多いなかで、医師としての成長をあきらめたくない。そんな声に、私たちもまだ完璧に応えられているとは言えません。
けれど、非常勤や時短勤務、柔軟な働き方の選択肢を少しずつ広げ、「今できること」を無理なく積み重ねていける仕組みを整えています。

後進育成

当科では大学病院としての教育機能を最大限に発揮するため、カリキュラム性で後進胆膵専門医育成を行っております。大分をはじめとする全国で活躍できる消化器内科医を育成するためには優れた診療技術・エビデンスを創出する能力・医療人としての人格の全てを兼ね備える必要があります。
関連病院
[ ↔ ] 表を左右にスクロールしてご確認ください。
| 施設名 | 日本内科学会 | 日本消化器病学会 | 日本消化器内視鏡学会 | 日本肝臓学会 |
|---|---|---|---|---|
| 大分赤十字病院 | ○(連携) | ○ | ○ | ○ |
| 独立行政法人国立病院機構 大分医療センター | ○(連携) | ○(関連) | ○ | ○(関連) |
| 大分市医師会立アルメイダ病院 | ○(連携) | ○ | ○ | |
| 大分県立病院 | ○(連携) | ○ | ○ | ○ |
| 社会医療法人敬和会 大分岡病院 | ○(連携) | ○(関連) | ○ | |
| 社会医療法人三愛会 大分三愛メディカルセンター | ○(連携) | ○(関連) | ○ | |
| 社会医療法人恵愛会 大分中村病院 | ○(連携) | ○ | ||
| 医療法人八宏会 有田胃腸病院 | ○(特別連携) | ○(関連) | ○ | |
| 大分県厚生連 鶴見病院 | ○(連携) | ○ | ○ | ○(関連) |
| 国家公務員共済組合連合会 新別府病院 | ○(連携) | ○ | ○ | ○(関連) |
| 中津市立中津市民病院 | ○(連携) | ○ | ○ | ○(関連) |
| 独立行政法人地域医療機能推進機構 南海医療センター | ○(連携) | ○(関連) | ○(連携) | |
| 臼杵市医師会立 コスモス病院 | ○(連携) | ○(連携) | ||
| 医療法人新生会 高田中央病院 | ○(特別連携) | ○(関連) | ○(連携) | |
| 杵築市立山香病院 | ○(連携) | ○(関連) | ||
| 宇佐高田医師会病院 | ○(特別連携) | ○(関連) | ||
| 豊後大野市民病院 | ○(連携) | ○ | ||
| 国東市民病院 | ○(特別連携) | ○(連携) | ○(特別連携) |
その他の医局員派遣病院
- 医療法人ウェルビーイング あべ胃腸内視鏡クリニック
- 医療法人博光会 塚川第一病院
- 医療法人凱風会 織部病院
- 医療法人展寿会 梶本医院
- 公益財団法人 大分県地域成人病検診協会 おおいた健診センター
- 大分県厚生連健康管理センター
- 医療法人恵愛会 中村病院
- 別府駅ゆのまち内科・胃と腸クリニック
- 医療法人和田胃腸科内科クリニック
- 医療法人恵友会 杵築中央病院
- 医療法人平成会 サンライズ酒井
- 医療法人啓燈会 玖珠記念病院
- 医療法人大分厚生会 川崎内科


